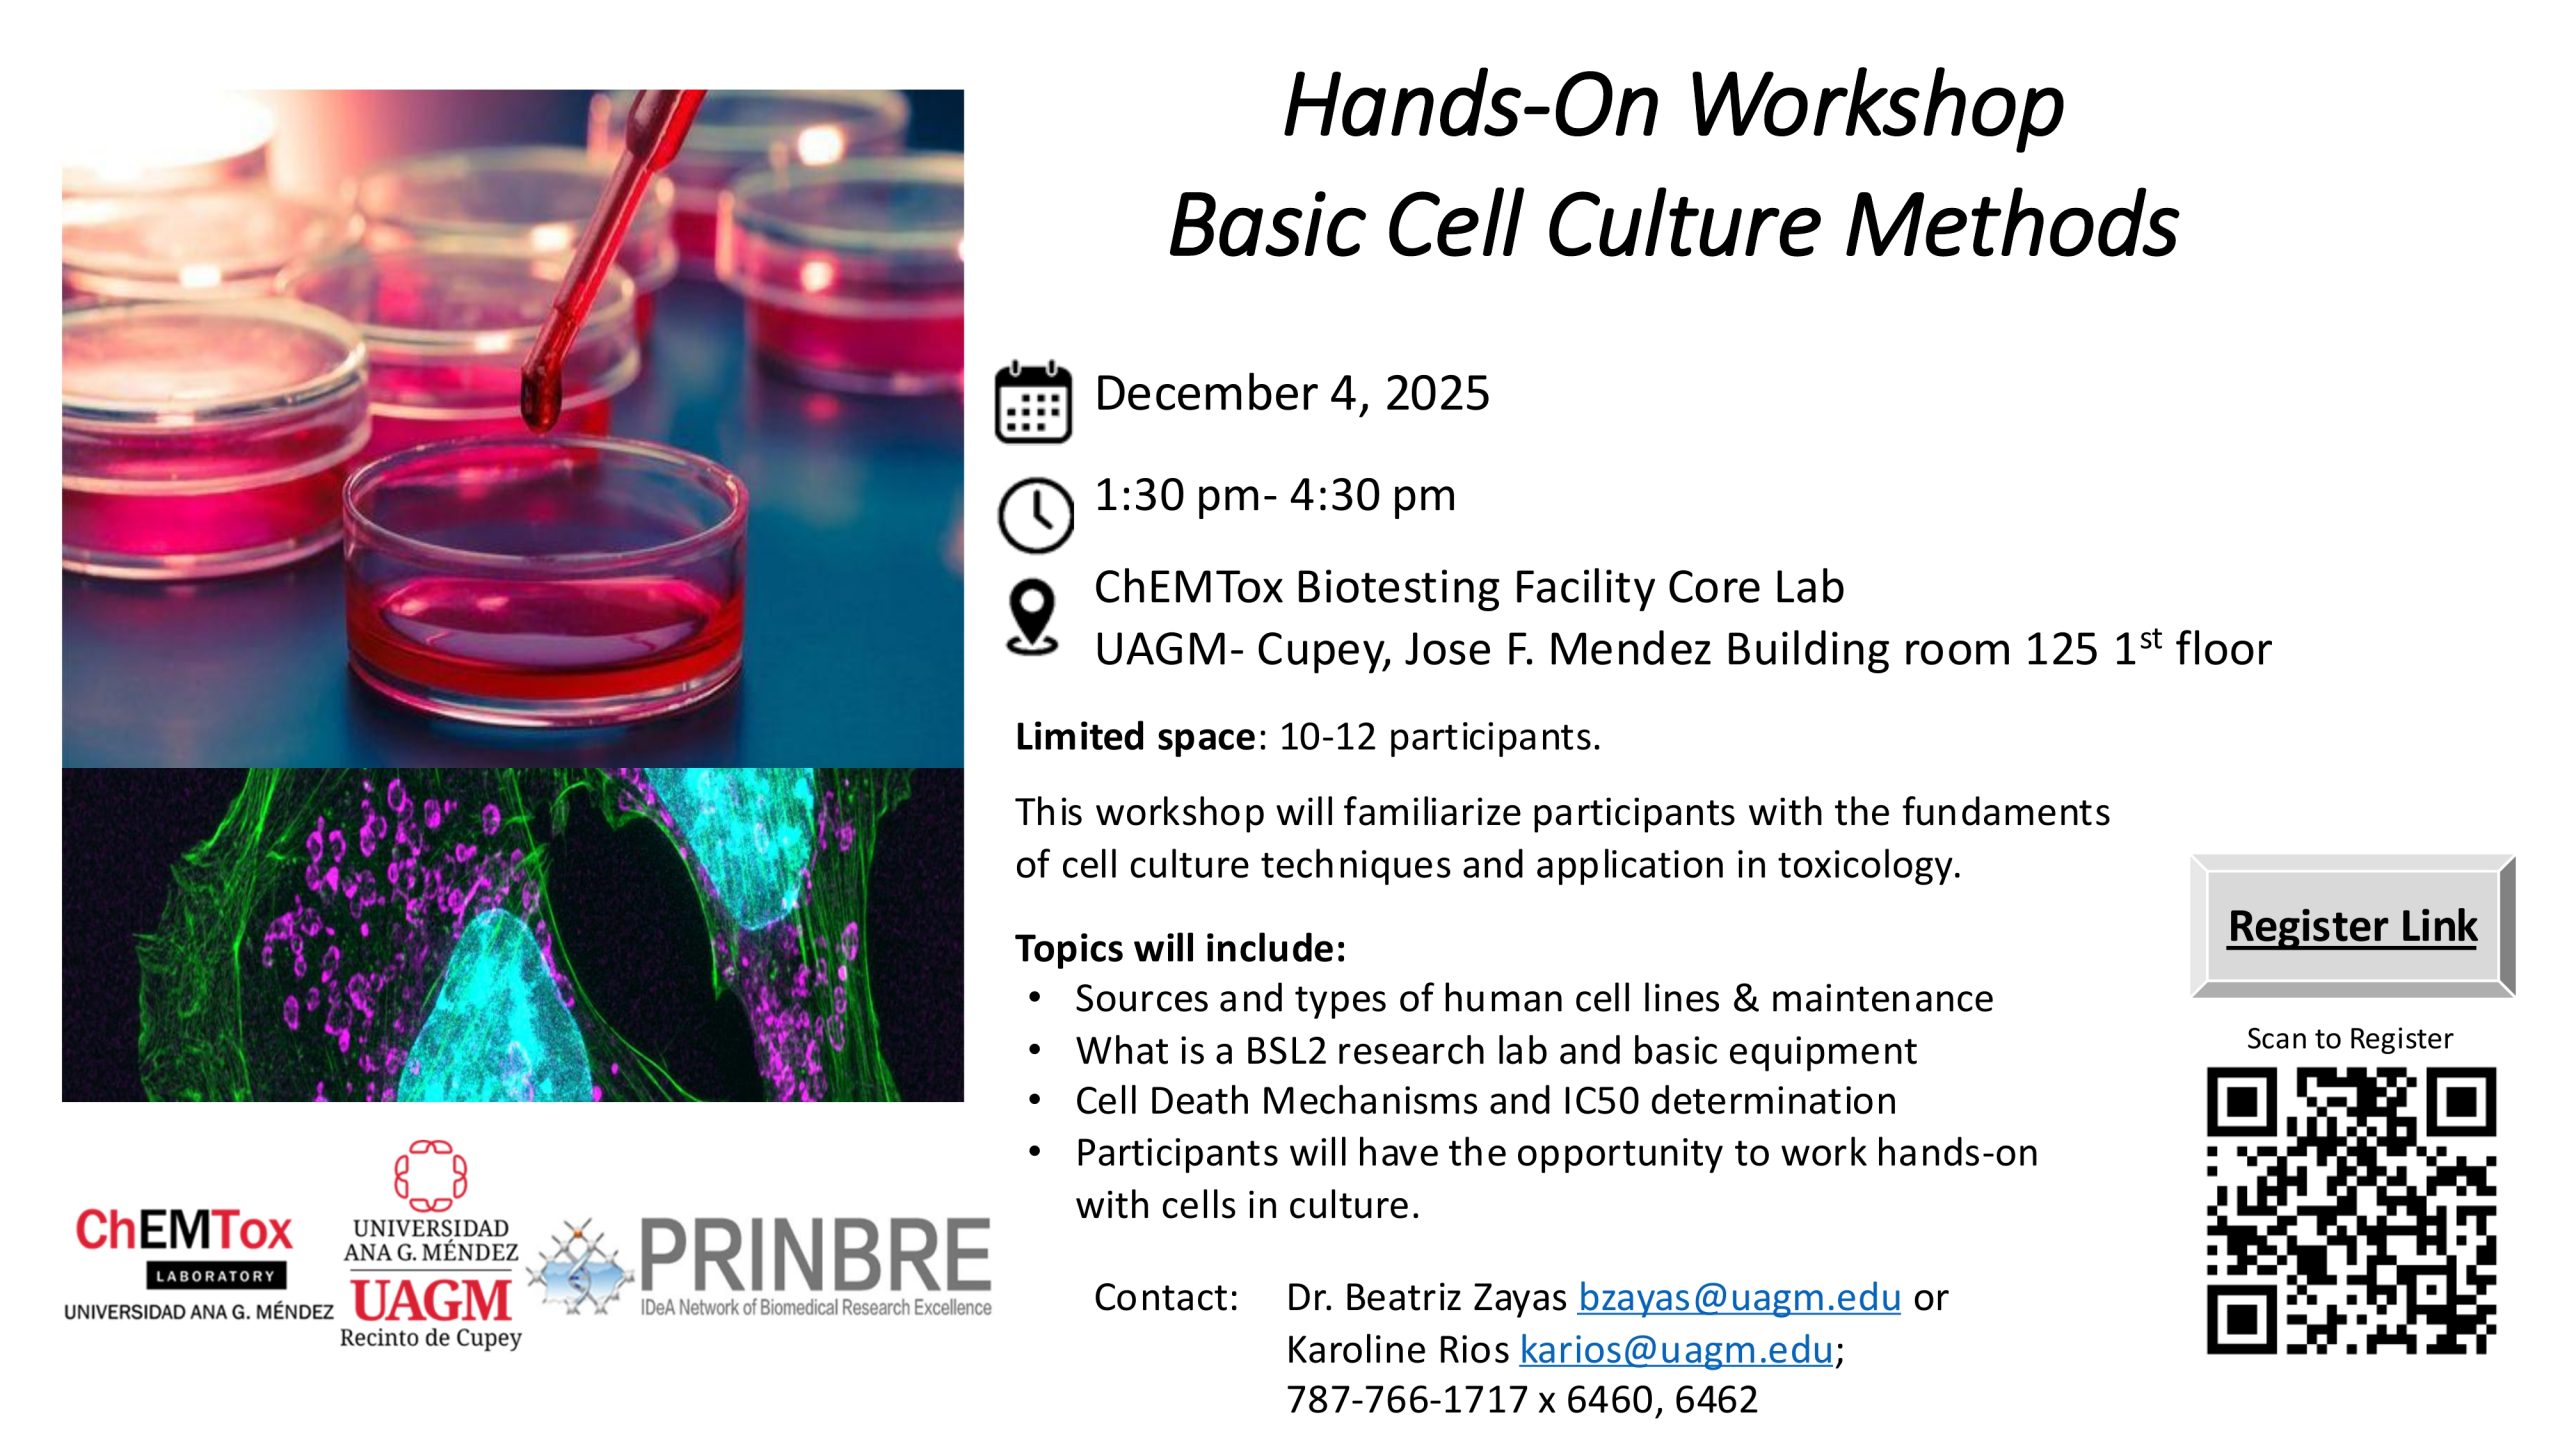

Events
Techniques and applications in proteomics

For all those who were unable to attend the seminar and would like to watch a it, you can access it through the following link. Proteomics Seminar
PHAGES, FIBER, AND THE FUTURE OF MICROBIOME SCIENCE

Click here to join ZOOM Meeting:
Seminar Tour Sciences (UAGM)

Click here to register.
Seminar Tour Sciences (RCM)

Clck here to register.
DISSECTING HOST–MICROBE INTERACTIONS: FROM METHODS TO MICROBIOTA-BASED INTERVENTIONS IN AGING AND DISEASE

Clck here to join ZOOM Meeting.
Multi-Center Meet-Up: Environment, Cancer, and Microbiome: Interdisciplinary Scientific Perspectives

We invite you to the upcoming multi-center meet-up, “Environment, Cancer, and Microbiome: Interdisciplinary Perspectives from Puerto Rico," hosted at the Molecular Sciences Building. This event will bring together leading local experts to explore the urgent intersections of environmental health, cancer disparities, and the microbiome.
The program will open with introductions from CARIB-CARES (NCI), and NIGMS COBREs CPCHE, and the Puerto Rico Center for Microbiome Sciences (PR-CMS), setting the stage for collaboration across our centers.
- Session One (CARIB-CARES) will address the impacts of climate hazards and air quality on cancer and public health. Topics include post-Hurricane Maria cancer prevention, air contamination, patient-linked environmental sampling, and regional resilience in the face of exposures such as Saharan dust.
- Session Two (CPCHE & Microbiome Centers) will focus on cancer health disparities in Hispanic communities and the emerging role of the microbiome in shaping disease outcomes.
The symposium will close with a multidisciplinary panel discussion, identifying joint initiatives, policy opportunities, and collaborative pathways forward.
We look forward to your participation in this important conversation that seeks to advance public health through collective action. We thank PR-INBRE, RCMI, CCAN, CCC, and the HPV interest group for joining us in this initiative.
Seminar: Vaginal Microbiome in Cervical Cancer Development and Response to Therapy

Dear all,
Please save the date and share with colleagues our announcement for the upcoming COBRE PR-Center for Microbiome Sciences Seminar:
📅 Tuesday, September 24th
🕚 11:00 AM
📍 Room A371, 3rd Floor, School of Medicine
We kindly ask you to register here.
For those unable to attend in person, a Zoom option will be available.
https://us06web.zoom.us/j/83979873052
We look forward to your participation and THANK the collaboration of other NIH center grants, especially PR-INBRE, for hosting ZOOM.
PATHS TO B CELL INMUNITY

Greetings to all,
The Science and Technology Competency and Education Core of the Puerto Rico IDeA Network of Biomedical Research Excellence (PR-INBRE) at the University of Puerto Rico, Medical Sciences Campus, invites you to attend the next seminar in the G-RISE Program Seminar Series: “Paths to B Cell Immunity”
Dr. Jeremy M. Boss
Professor and Chair, Department of Microbiology and Immunology
Emory University School of Medicine
This seminar is part of the Seminar Tour 2025 and will take place on:
📅 Tuesday, June 24, 2025
📍 University of Puerto Rico – Medical Sciences Campus – Amphitheater, 6th Floor
We hope to see you there!
Segundo Congreso de Inmunología del Cáncer e Inmunoterapias – June 18, 2025

Segundo Congreso de Inmunología del Cáncer e Inmunoterapias
Greetings,
You are cordially invited to attend the Segundo Congreso de Inmunología del Cáncer e Inmunoterapias, which will take place on Wednesday, June 18, 2025, from 8:00 a.m. to 1:00 p.m. at the ADEM Building Amphitheater of the University of Puerto Rico at Humacao.
This event aims to bring together healthcare professionals, researchers, students, patients, caregivers, and the broader community to engage in meaningful dialogue about the critical role of the immune system and innovative treatments in the fight against cancer. The program will feature clinical and scientific presentations, an industry-led session, patient narratives, and a student poster session. For more details, please see the attached flyer.
To register, kindly visit https://forms.gle/yD6Jfd4VYkLpNLFt8.
For further information, please contact Dr. Kevin M. Alicea-Torres at kevin.alicea@upr.edu.
BioXFEL – FROM GENE TO STRUCTURE WORKSHOP

Click the following link to view workshop agenda: Agenda
Click the following link to register: Registration
Hands-On Workshop Basic Cell Culture Methods

To register, please visit: https://www.eventbrite.com/o/chemtox-laboratory-uagm-cupey-in-collaboration-with-prinbre-54427734723
New Microarray Tools for Genome and Gene Expression Analysis

Join Zoom Meeting
https://us06web.zoom.us/j/88192851373?pwd=4jiZoxoh6XOwm2acPJIJpgM7MzJyPc.1
ID de reunión: 881 9285 1373
Passcode: 978602
4th Undergraduate Summer Internship Orientation

Meeting Registration:
Click here to register for this event.
Seminar: Is There Really “Good” and “Bad” Cholesterol?

Join Zoom Meeting
Link: https://us06web.zoom.us/j/86459145401?pwd=iYzBaNg7PhF4l2I8SmrCf3aOoZHlF9.1
Meeting ID: 864 5914 5401
Passcode: 837791
PRINBRE CRI Core Facilities Seminar

Join Zoom Meeting:
Link: https://us06web.zoom.us/j/88192851373?pwd=4jiZoxoh6XOwm2acPJIJpgM7MzJyPc.1
Meeting ID: 881 9285 1373
Passcode: 978602
ASGSR 2024 Pre-Conference Workshop

The “Science and Technology Competency and Education Core – Puerto Rico IDeA Network of Biomedical Research Excellence" of the University of Puerto Rico Medical Sciences Campus encourages you to participate in the: NASA ISS National Lab Workshop Building a Collaborative Network for Biomanufacturing and Advanced Materials Innovation in Space
Date: 12/04/2024, 8:30 am – 1:00 pm
Location: Sheraton San Juan – Room Bahia 1&2
This Workshop is free of charge.
For In-person attendance:
https://www.eventbrite.com/e/asgsr-2024-pre-conference-workshop-tickets-1089951687839?aff=oddtdtcreator
For Virtual attendance:
https://issnationallab.zoom.us/webinar/register/WN_DKfzKOAYQH2fMiKrf5aaDQ
Overview:
The 2024 American Association for Gravitational and Space Research Pre-Conference Workshop is the last of the 2024 biomanufacturing and advanced materials in space workshop trilogy (the first was at ISSCR and the second at ISSRDC) to raise awareness about the value of space-based R&D and the critical need for workforce development to prepare the next generation of scientists and engineers. This workshop aims to unite key stakeholders from innovation hubs, research institutions, industry, and government agencies to create a collaborative network to leverage the space environment to advance biomanufacturing and advanced materials technologies. This workshop provides a platform to expand existing and establish new strategic partnerships that will shape the future of biomanufacturing and advanced materials in space, with a special focus on the unique challenges and opportunities of conducting R&D in low Earth orbit.
We encourage prospective and current NASA-funded researchers and students to attend.
47th ACS Senior Technical Meeting

The “Science and Technology Competency and Education Core – Puerto Rico IDeA Network of Biomedical Research Excellence" of the University of Puerto Rico Medical Sciences Campus will sponsor the Meeting: FROM BENCH TO MARKET: HARNESSING CHEMICAL TOOLS FOR DEVELOPING DRUGS, DIAGNOSTIC AGENTS, AND BIOSENSORS. This meeting is part of the 47th ACS Senior Technical Meeting which will take place on Saturday, November 16, 2024, at the Embassy Suites Hotel, San Juan PR.
STCE Core will cover registration for students who submit abstracts and request financial assistance to participate. Please send evidence of your abstract submission and a letter of recommendation from your mentor to sandra.charriez@upr.edu.
For the deadline and additional information, please click on the following links:
Computational Approaches to Drug Target Discovery and Validation Workshop

Click the following link to download a PDF version of the workshop outline: Workshop Outline
Click the following link to download the workshop presentation in PDF format: Workshop Presentation
Identification of biologically active Ganoderma lucidum compounds in aggressive breast cancer models

Dr. Sean B. Carroll is visiting the UPR-Río Piedras

Dr. Sean B. Carroll is visiting the UPR-Río Piedras
Individual Development and Experimental Design Plans: Life-Time Integrated Skills

Seminar offered by Dr. Juan López Garriga. Date: Saturday, Nov 05, 2022 – Time: 9:00AM – 3:00PM – Place: UPR-Cayey, Science Building, Amphitheater (NEC).
SEMINAR TOUR SERIES

SEMINAR TOUR SERIES
The “STCE Core – PRINBRE” of the University of Puerto Rico Medical Sciences Campus will be hosting the seminar entitled: “Lanifibranor (a pan-PPAR agonist) improves markers of cardiometabolic health and glycemic control in patients with NASH”. Our speaker Dr. Michael Cooreman, is the Chief Medical Officer from Inventiva Pharma.
The seminar will take place on Thursday, October 06, 2022, at 12:00PM to 1:00PM
in the UPR-MSC 6th floor Room 622.
Click here to access ZOOM videoconference.
Password: 324256
LINUX WORKSHOP PART I

LINUX WORKSHOP PART I
Boquerón Cluster Operating System for Bioinformatics & Computation
- Location: Pontificia Universidad Católica de Puerto Rico, Ponce
- Date: Friday September 16, 2022
- Time: 1:00 – 4:00 PM
- Room: FE-206
LINUX WORKSHOP PART II

LINUX WORKSHOP PART II
Boquerón Cluster Operating System for Bioinformatics & Computation
- Location: Pontificia Universidad Católica de Puerto Rico, Ponce
- Date: Friday October 7, 2022
- Time: 1:00 – 4:00 PM
- Room: FE-206
LINUX WORKSHOP PART III

LINUX WORKSHOP PART III
Boquerón Cluster Operating System for Bioinformatics & Computation
- Location: Pontificia Universidad Católica de Puerto Rico, Ponce
- Date: Friday October 28, 2022
- Time: 1:00 – 4:00 PM
- Room: FE-206
1st Summer Internship Program

1st Summer Internship Program
The STCE is pleased to invite you to participate in the first Summer Internship Program Poster Presentation to be held at the Conrado F. Asenjo Library at the University of Puerto Rico – Medical Sciences Campus. This next Friday, August 12, 2022 at 3:30 PM.
11ma Conferencia Anual Concilio Americano de Plantas con Actividad Medicinal

11ma Conferencia Anual Concilio Americano de Plantas con Actividad Medicinal
Invitado Especial: Dr. David Julius, Premio Nobel – Filosofía 2021
Fecha: 28 junio- 2 julio
Lugar: Recintos Univ. Interamericana Barraquitas y Bayamón
DISSECTING HOST–MICROBE INTERACTIONS: FROM METHODS TO MICROBIOTA-BASED INTERVENTIONS IN AGING AND DISEASE

Clck here to join ZOOM Meeting.